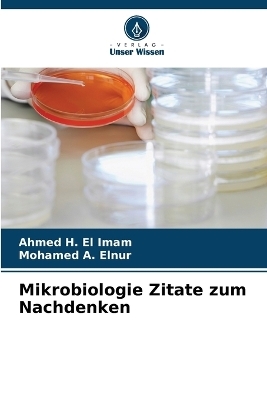
Mikrobiologie Zitate zum Nachdenken - Ahmed H El Imam, Mohamed A

Mikrobiologie Zitate zum Nachdenken
Seiten
2025
Verlag Unser Wissen
9786208750848 (ISBN)
Verlag Unser Wissen
9786208750848 (ISBN)
- Titel nicht im Sortiment
- Artikel merken
"Microbiology Quotable Quotes" fasst die grundlegenden Informationen zur allgemeinen und systemischen Mikrobiologie zusammen, ordnet sie und vereinfacht sie. Dieses Buch ist von großem Interesse, da es so konzipiert ist, dass die Informationen zugänglicher, klarer und einheitlicher sind. Außerdem wurden mehrere Anstrengungen unternommen, um die Lesbarkeit des Textes zu verbessern, sodass alle Studierenden, postgradualen Mediziner, Wissenschaftler und Fachkräfte im Gesundheitswesen mit geringem Aufwand Wissen erwerben können. Dieses Buch wurde in erster Linie zur Aktualisierung, Neuorganisation und Neuausrichtung auf bakterielle, virale und parasitäre Krankheiten verfasst. Abschnitt 1 behandelt die grundlegenden mikrobiologischen Konzepte und Abschnitt 2 die genauen Details der verschiedenen mikrobiologischen Krankheiten. Das Buch untersucht, wie die Zitate die wesentlichen Tipps und Faktenblätter zu Krankheiten und ihrer Pathogenese, Epidemiologie, Diagnose, Kontrolle und Behandlung besser zusammenfassen können, und setzt dabei auf eine frühzeitige Diagnose, eine schnelle Behandlung, Kontrolle und zukünftige Ausrottung.
Ahmed H. El Imam: BVSc., MVSc., PhD. Universität Khartum, Sudan. Fachbereich Mikrobiologie, College of Med. Angewandte Wissenschaften, Jazan Universität, Saudi-Arabien. A. Mohamed A. Elnur: BVSc., Universität Khartum. DVSM., Universität Edinburgh. Fachbereich Mikrobiologie, Fakultät für Medizin und Gesundheitswissenschaften, Universität Elimam Elmahadi, Sudan.
| Erscheinungsdatum | 20.03.2025 |
|---|---|
| Sprache | deutsch |
| Maße | 152 x 229 mm |
| Gewicht | 186 g |
| Themenwelt | Naturwissenschaften ► Biologie ► Allgemeines / Lexika |
| Naturwissenschaften ► Biologie ► Mikrobiologie / Immunologie | |
| Schlagworte | allgemeine Mikrobiologie • Systemische Mikrobiologie • Zitate |
| ISBN-13 | 9786208750848 / 9786208750848 |
| Zustand | Neuware |
| Informationen gemäß Produktsicherheitsverordnung (GPSR) | |
| Haben Sie eine Frage zum Produkt? |
Mehr entdecken
aus dem Bereich
aus dem Bereich
Buch | Softcover (2024)
Wiley-VCH (Verlag)
CHF 55,85
Band 2: Elektrizität, Optik und Wellen
Buch | Softcover (2022)
Wiley-VCH (Verlag)
CHF 55,85
Vom Ursprung der Sexualitat zum modernen Menschen
Buch | Softcover (2025)
UTB (Verlag)
CHF 54,60


